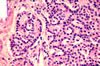

| Paratiroid |

Paratiroid |
Paratiroid |

Paratiroid |
| Paratroit bezinden salgılanan, kalsiyumun bağırsaktan emilimini, böbreklerden atılmasını, kemiklerden serbest hale geçirilmesini ve hücreler arasındaki kalsiyum iyon konsantrasyonunu kontrol eden hormon. |